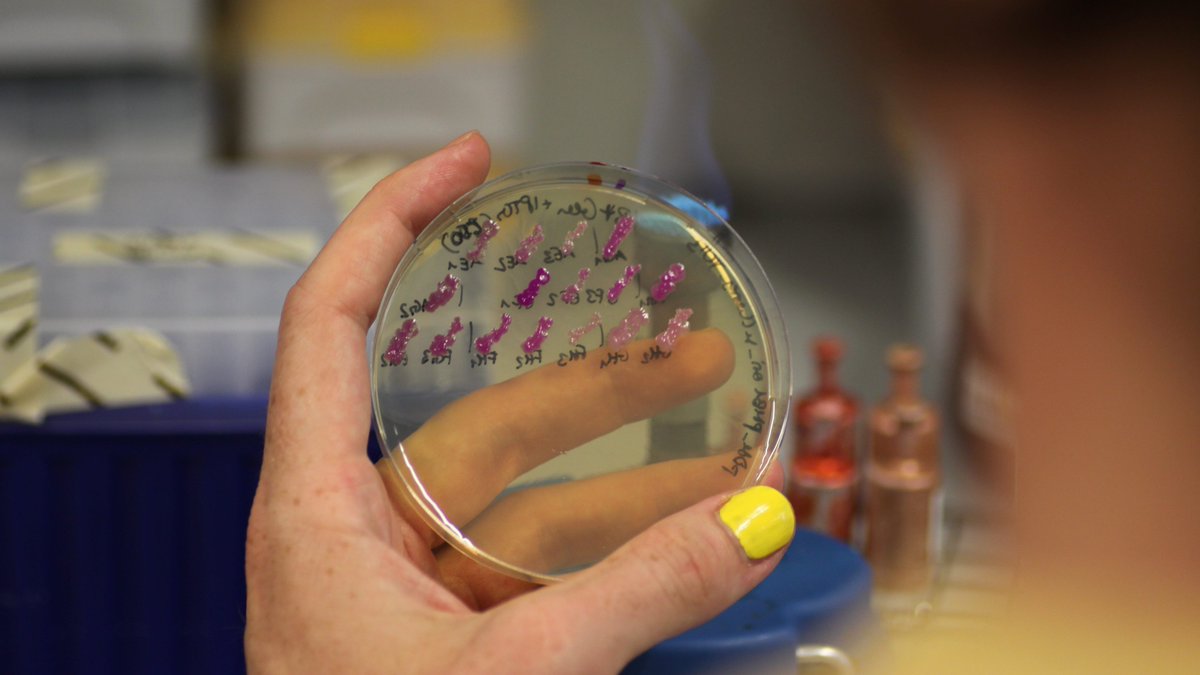
Statt Erdöl &amp; Acker: Ein Team der #CharitéBerlin hat neue Bakterienstämme entwickelt, die chemische Stoffe aus Industrieabfall produzieren können. So ließen sich z.B. #Bioplastik &amp; #Biokraftstoffe nachhaltiger herstellen. Viva la Fossilfreiheit! @lindlichs charite.de/forschung/pape…

Julia Muenzner
@juliamuenzner
@juliamuenzner.bsky.social
Proteomics and systems biology in yeast 🦠💻 Postdoc @RalserLab @ChariteBerlin. PhD in virology @Cambridge_Uni 👩🏼🔬
ID: 1147227727465975808
05-07-2019 19:36:19
1,1K Tweet
386 Takipçi
522 Takip Edilen



📢 Wo ist unser Geld, VBL? Warum gibt es keine Transparenz? Wir fordern: Offenlegung fossiler Investitionen und nachhaltige Kapitalanlage! ➡️ sustainvbl.de Nutze das E-Mail-Tool & fordere Aufklärung: finanzwende.de/kampagnen/vbl-… #VBLforfuture #WoistUnserGeld Finanzwende



Very happy to share our latest papers on the identification of novel dependencies of aneuploid cells just published in Nature Communications and Cancer Discovery!A work jointly conceived by Stefano Santaguida and the Ben-David Lab and beautifully executed by talented Marica Ippolito 🧬 and Johanna


It is not trivial to make the right amount of histones in different nutrients, when #cellsize, growth rate, and S-phase duration change. Still, budding yeast manages by regulating transcription and translation: doi.org/10.1038/s44318… Francesco Padovani

New preprint from the Schacherer Lab! Here, we revisit the population structure somewhat. But the main objective is rather to have a resource for the community around 3,034 genomes, capturing ~93% of the genetic diversity of the S. cerevisiae species. biorxiv.org/content/10.110…



Our ScRAPdb paper is finally out at Nucleic Acids Res > academic.oup.com/nar/advance-ar… , in which we assembled a #pangenome x #multiomics database for the iconic model organism S. cerevisiae. This is one step forward for the ScRAP project and we expected many more to come. Read more >

Job klaxon - we have an Assistant Professor post (Research and Education) in Molecular Microbiology UoB Biosciences IMIBirmingham open. Come and join us at Birmingham… edzz.fa.em3.oraclecloud.com/hcmUI/Candidat…




"In what was the first known case of an employee being fired for refusing to take a plane to reduce greenhouse gas emissions, a climate researcher has been now awarded a payout." 🙏Juliette Rowsell for telling my story on Times Higher Education. 👉timeshighereducation.com/news/researche…